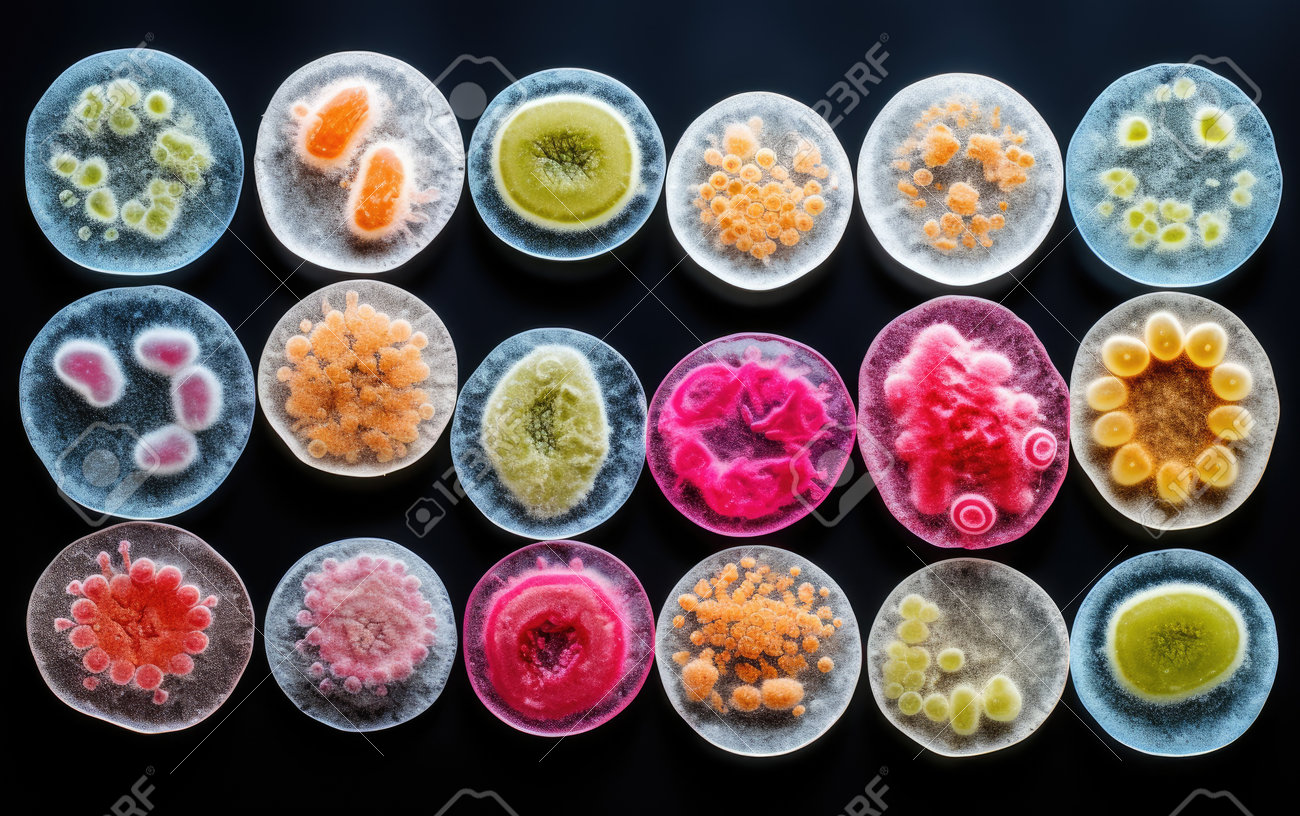
etiam-dictum-ipsum-a-felis

Download
Close
Автор:
id:
Ключевые слова:
bacillus, bacterium, battlefield, battling, beyond, bug, challenge, challenges, confronting, dangers, detecting, exposed, eye, germ, hidden, intricacies, intruders, invaders, invisible, menace, microbial, minefield, mold, naked, navigating, pathogenic, pathogens, perils, revealed, revelation, threats, unmasking, unseen, unveiling, virus,





